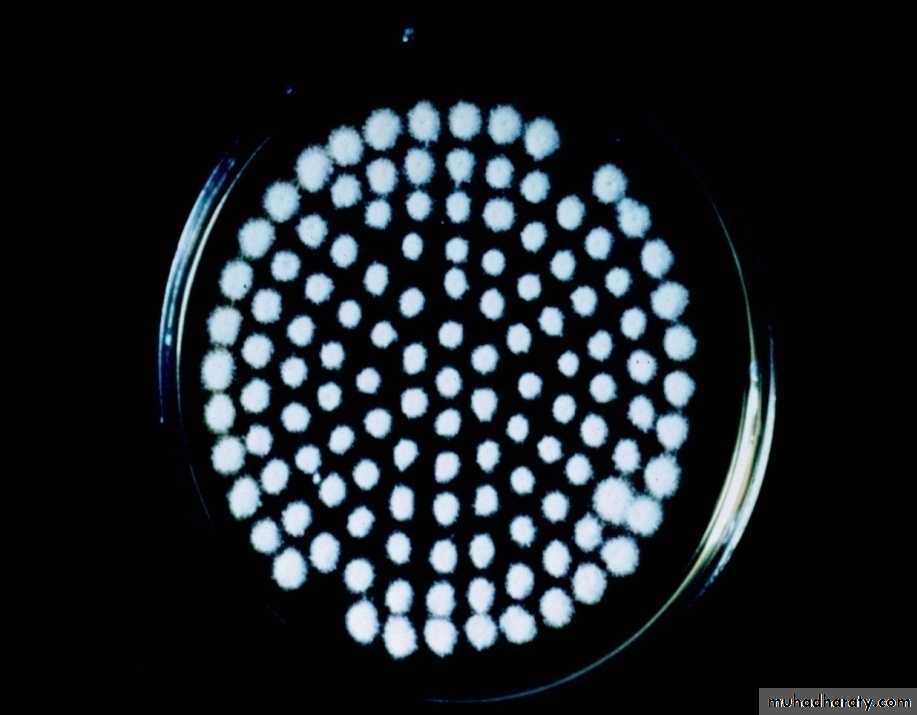
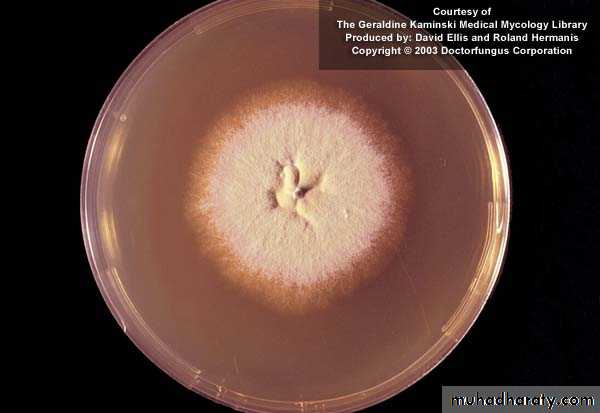
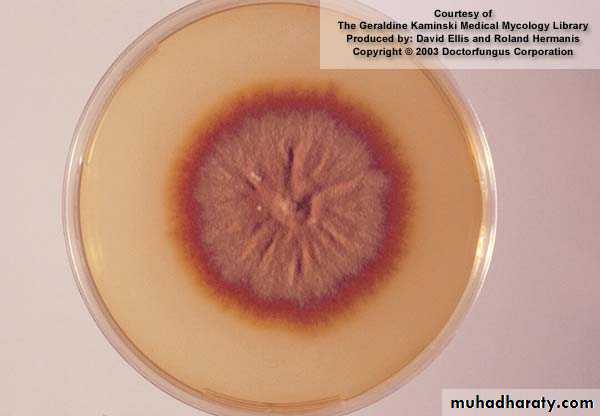
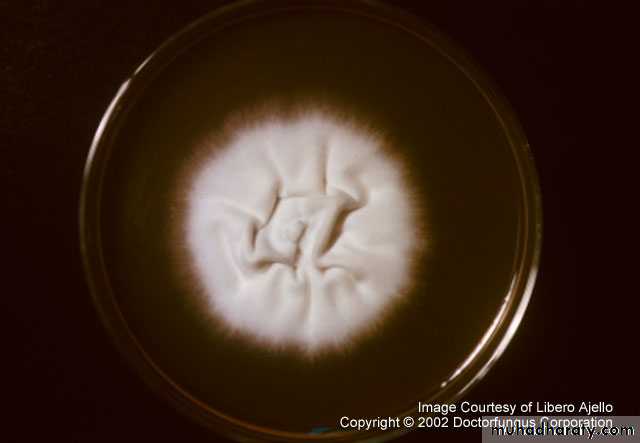
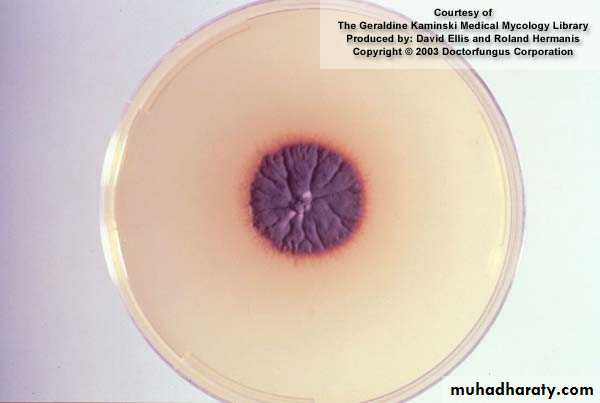
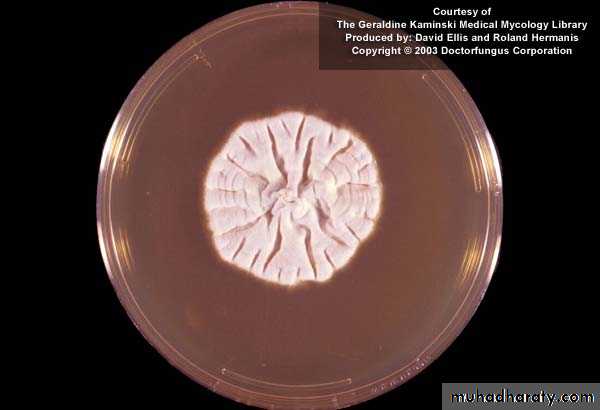
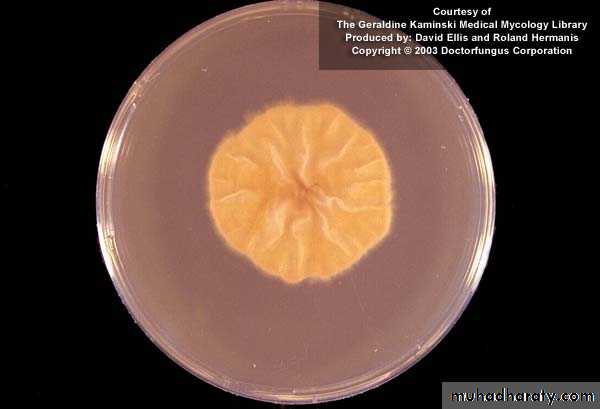
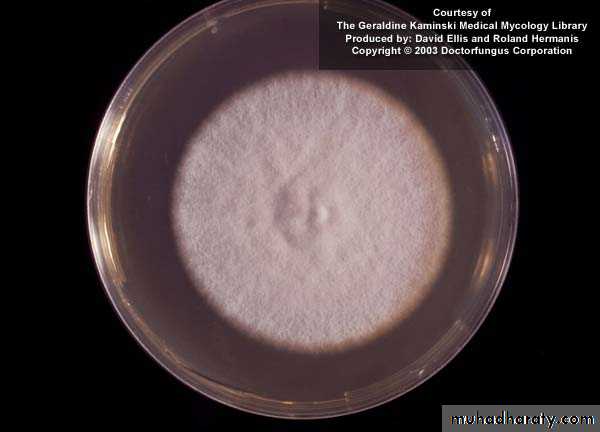
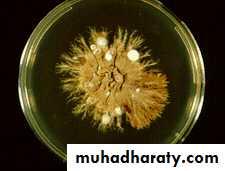
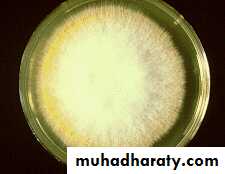
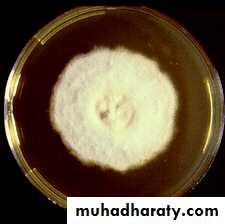

Fungal Infections
Dermatophyte infections (ringworm)Cause:
Three genera of dermatophyte fungi cause tinea infections (ringworm).
Trichophyton-skin, hair and nail infections
Microsporum-skin, and hair.
Epidermophyton-skin and nails.
Fungal Infections
Dermatophytes invade only into the stratum corneum, and the inflammation they cause is a result of metabolic products of the fungus or delayed hypersensitivity. In general, zoophilic fungi (those transmited to humans by animals) cause a more severe inflammation than anthropophilic ones (spread from person to person).Fungal Infections
Presentation and courseThis depends upon the site and on the strain od fungus involved.
Tinea pedis (athlete,s foot)
This is the most common type of fungal infection in humans. The sharing of wash places (e.g. in showers) and of swimming pools predisposes to infection; spores in occlusive footwear encourage relapses.
Tinea Pedis – Athlete’s Foot Infection
Fungal Infections
Most cases are caused by one of three organisms:Trichophyton rubrum (the most common and the most stubborn), Trichophyton mentagrophytes var. interdigitale and Epidermophyton floccosum.
There are three common clinical patterns:
1 Soggy interdigital scaling, particularly in the forth and fifth interspace (all three organisms)
2 A diffuse dry scaling of the soles (usually T. rubrum)
3 Recurrent episodes of vesication (usually T. mentagrophytes var. interdigitale or E. floccosum).
Fungal Infections
Tinea of the nailsToe nail infection is usually associated with tinea pedis. The initial changes occur at the free edge of the nail, which becomes yellow and crumbly. Subungual hyperkeratosisi, separation of the nail from its bed and thickening may then follow. Usually, only a few nails are infected but rarely all are. Finger nail lesions are similar, but less common, and are seldom seen without a chronic T. rubrum infection of the skin of the same hand.
Tinea Unguium – Nail Infection
Tinea unguium(nails)
Fungal Infections
Tinea of the handsThis is usually asymmetrical and associated with tinea pedis and unilateral onychomycosis. Trichophyton rubrum may cause a barely perceptible erythema of one palm with a characteristic powdery scale in the creases.
Tinea of the groin
This is common and affects men more often than women. The eruption is sometimes unilateral or asymmetrical. The upper inner thigh is involved and lesions expand slowly to form sharply demarcated plaques with peripheral scaling. In contrast to candidiasis of the groin area, the scrotum is usually spread. A few vesicles or pustules may be seen within the lesions. The organisms are the same as those causing tinea pedis.
Tinea Cruris – Jock Itch
Fungal Infections
Tinea of the trunk and limbsTinea corporis is characterized by plaques with scaling and erythema most pronounced at the periphery. A few small wesicles and pustules may be seen within them. The lesions expand slowly and healing in the centre leaves a typical ring-like pattern. In some patients the fungus elicits almost no inflammation, in wich case the infection is a marginated patch of rough scaling skin.
Tinea corporis – body ringworm
Fungal Infections
Tinea of the scalpThis is usually a disease of children. The causative organism varies from country to country. Fungi coming from human sources (anthropophilic organisms) cause bald and scaly areas, with minimal inflammation and hairs broken off 3—4 mm from the scalp.
Fungi coming from animal sources (zoophilic fungi) induce a more intense inflammation than those spread from person to person. The ringworm acquired from cattle, for example, the boggy swelling, with inflammation, postulation and lymphadenopathy, is often so fierce that a bacterial infection is suspected; such a lesion is called a kerion and the hair loss associated with it may be permanent. Tinea of the beard area is usually caused by zoophilic species and shows the same features. In favus, caused by trichophyton schoenleini, the picture is dominated by foul-smelling yellowish crusts surrounding many scalp hairs, and sometimes leading to scarring alopecia. The scalp and hair of black children are especially prone to infection with Trichophyton tonsurans.
Tinea Capitis
Gray Patch
Fungal InfectionsComplications
1 Fierce animal ringworm of the scalp can lead to a permanent scarring alopecia.
2 A florid fungal infection anywhere can induce vesication on the sides of the fingers and palms (a trichophytid or 'id reaction').
3 Epidemics of ringworm occure in schools.
4 The usual appearance of a fungal infection can be masked by mistreatment with topical steroids (tinea incognito).
Fungal Infections
Differential diagnosisThe varies with the site. Some of the more common problems are listed in this table:
scalp
Alopecia areanta, psoriasis, seborrhoeic eczema, carbuncle, abscess, trichotillomania
Feet
Erythrasma, interdigital intertrigo, eczema
Trunk
Discoid eczema, psoriasis, candidiasis, pityriasis rosea
Groin
Candidiasis, erythrasma, intertrigo, irritant and allergic contact dermatitis, psoriasis, neurodermatitis
Nails
Psoriasis, paronychia, trauma, ageing changes
Hand
Chronic eczema, granuloma annulare, xerosis, dyshidrotic eczema
Fungal Infections
Investigations
The microscopic examination of a skin scraping, nail clipping or plucked hair is a simple procedure. The scraping should be taken from the scaly margin of a lesion, with a small curette or a scalpel blade, and clippings or scrapings from the most crumbly part of a nail. Broken hairs should be plucked with tweezers. Specimens are cleared in potassium hydroxide. Branching hyphae can easily be seen using a scanning (x10) or low-power (x25) objective lens, with the iris diaphragm almost closed and the condenser racked down. Hyphae may also be seen within a cleared hair shaft, or spores may be noted around it.
141
142
Fungal Infections
Cultures should be carried out in a mycology or bacteriology laboratory. Transport medium is not necessary, and specimens can be sent in folded black paper or a dry Petri dish. The report may take as long as a month; microscopy is much quicker.Wood's light (ultraviolet light) examination of the scalp usually reveals a green fluorescence of the hairs in Microdporum audouini and M. canis infections. The technique is useful for screening children in institutions where outbreaks of tinea capitis still sometimes occur, but the most common fungus causing tinea capitis (Trichophyton tonsurans) does not fluoresce.
Dermatophyte Culture
Dermatophyte Culture
Dermatophyte Culture
Trichophyton tonsurans
http://www.mycology.adelaide.edu.au/Fungal_Descriptions/Dermatophytes/Trichophyton/tonsurans.html
Trichophyton violaceum
http://www.mycology.adelaide.edu.au/Fungal_Descriptions/Dermatophytes/Trichophyton/violaceum.html
Trichophyton verrucosum
http://www.mycology.adelaide.edu.au/Fungal_Descriptions/Dermatophytes/Trichophyton/verrucosum.html
Trichophyton mentagrophytes
http://www.mycology.adelaide.edu.au/Fungal_Descriptions/Dermatophytes/Trichophyton/mentagrophytes.html
Epidermophyton floccosum
http://www.mycology.adelaide.edu.au/Fungal_Descriptions/Dermatophytes/Epidermophyton/http://www.doctorfungus.org/thefungi/epidermophyton.htm
Microsporum canisTeleomorph: Arthroderma otae
http://www.doctorfungus.org/thefungi/microsporum_canis.htm
http://www.mycology.adelaide.edu.au/Fungal_Descriptions/Dermatophytes/Microsporum/Microsporum_canis.htmlTrichophyton schoenleinii
http://www.mycology.adelaide.edu.au/Fungal_Descriptions/Dermatophytes/Trichophyton/schoenlenii.html
Microsporum audouinii
http://www.doctorfungus.org/thefungi/microsporum_audouinii.htm
http://www.mycology.adelaide.edu.au/Fungal_Descriptions/Dermatophytes/Microsporum/Microsporum_audouinii.html145
Ectothrix and Endothrix
Fluorescing hair (under Wood's lamp) is seen in dogs and cats infected with some dermatophytes
Fungal Infections
Treatment
Local
This is all that is needed for minor skin infections. The more recent imidazole preparations (e.g. miconazole and clotrimazole) and the allylamines such as terbinafine have largely superseded time-honoured remedies such as benzoic acid ointment (whitfield's ointment) and tolnaftate. They should be applied twice daily. Magma paint (Castellsni's paint), although highly coloured, is helpful for exudative or macerated areas in body folds or toe webs. Occasional dusting with an anti-fungal powder is useful to prevent relapses.
Fungal Infections
Topical nail preparations Many patients now prefer to avoid systemic treatment. For them a nail lacquer containing amorolfine is worth a trial. It should be applied once or twice a week for 6 month; it is effective against stubborn moulds such as Hendersonula and Scopulariopsis. Ciclopirox is an alternative topical treatment available in the USA. Both amorolfine and tioconazole nail solutions can be used as adjuncts to systemic therapy.Fungal Infections
SystemicThis is needed for tinea of scalp or of the nails, and for widespread or chronic infections of the skin that have not responded to local measures.
Terbinafine has now largely superseded griseofulvin. It acts by inhibiting fungal squalene epoxidase and does not interact with the cytochrome P450 system. It is fungicidal and so cures chronic dermatophyte infections more quickly and more reliably than grisofulvin. For tinea capitis in children, for example, a 4-week course of griseofulvin. Cure rates of 70-90% can be expected for infected finger nails after a 6-week course of terbinafine, and for infected toe nails after a 3-month course. It is not effective in pityriasis versicolor or Candida infections.
Fungal Infections
Itraconazole is now preferred to ketoconazole, which occasionally damages the liver, and is a reasonable alternative to terbinafine if this is contraindicated. It is effective in tinea corporis, cruris and pedis and also in nail infections. Fungistatic rather than fungicidal, it interferes with the cytochrome P450 system, so a review of any other medication being taken is needed before a prescription is issued. Its wide spectrum makes it useful also in pityriasis versicolor and candidiasis.Fungal Infections
Griseofulvin was for many years the drug of choice for chronic dermatophyte infections, but is now largely reserved for the treatment of tinea capitis. It has proved to be a safe drug, but treatment may have to be stopped because of persistant headache, nausea, vomiting or skin eruptions. The drug should not be given in pregnancy or to patients with liver failure or porphyria. It interacts with coumarin anticoagulants, the dosage of which may have to be increased.Therapy
GriseofulvinTinactin
Clotrimazole
Miconazole
Ketoconazole
Itraconazole
Terbinafine
Fungal Infections
Candidiasis
Cause
Candida albicans is a classic opportunistic pathogen. Even in transient and trivial local infections in the apparently fit, one or more predisposing factors such as obesity, moisture and maceration, immobility, diabetes, pregnancy, the use of broad-spectrum antibiotics, or perhaps the use of the contraceptive pill, will often be found to be playing some part. Opportunism is even more obvious in the overwhelming systemic infections of the immune-compromised.
Fungal Infections
PresentationThis varies with the site:
Oral candidiasis
One or more whitish adherent plaques (like bread sauce) appear on the mucous membranes. If wiped off they leave an erythematous base. Under dentures, candidiasis will produce sore red areas. Angular stomatitis, usually in denture wears, may be candidal.
Fungal Infections
Candida intertrigoA moist glazed area of erythema and maceration appears in a body fold; the edge show a soggy scaling, and outlying satellite papulopustules. These changes are most common under the breasts, and in the armpits and groin, but can also occur between the fingers of those whose hands are often in water.
Fungal Infections
Genital candidiasisMost commonly presents as a sore itchy vulvo-vaginitis, with white curdy plaques adherent to the inflamed mucous membranes and a whitish discharge. The eruption may extend to the groin folds. Conjugal spread is common; in males, similar changes occur under the foreskin and in the groin.
Diabetes, pregnancy and antibiotic therapy are common predisposing factors.
Fungal Infections
ParonychiaAcute paronychia is usually bacterial, but in chronic paronychia Candida may be the sole pathogen, or be found with other opportunists such as Proteus or Pseudomonas sp. The proximal and sometimes the lateral nail folds of one or more fingers become bolstered and red. The cuticles are lost and small amounts of pus can be expressed. The adjacent nail plate becomes ridged and discoloured. Predisposing factors include wet work, poor peripheral circulation and vulval candidiasis.
Fungal Infections
Chronic mucocutaneous candidiasisPersistent candidiasis, affecting most or all of the areas described above, can start in infancy. Sometimes the nail plates as well as the nail folds are involved. Candida granulomas may appear on the scalp. Several different forms have been described including those with autosomal recessive and dominant inheritance patterns. In the Candida endocrinopathy syndrome, chronic candidiasis occurs with one or more endocrine defects, the most common of which are hypoparathyroidism and Addison's disease. A few late-onset cases have underling thymic tumours.
Fungal Infections
Systemic candidiasis
This is seen against a background of severe illness, leucopenia and immunosuppression. The skin lesions are firm red nodules, which can be shown by biopsy to contain yeast and pseudohyphae.
Fungal Infections
InvestigationsSwabs from suspected areas should be sent for culture. The urine can be tested for sugar. Tn chronic mucocutaneous candidiasis, a detailed immunological work-up will be needed, focusing on troubles associated with cell-mediated immunity.
Fungal Infections
TreatmentPredisposing factors should be sought and eliminated (e.g. denture hygiene may be important). Infected skin folds should be separated and kept dry. Those with chronic paronychia should keep their hands warm and dry.
Fungal Infections
Amphotericin, nystatin and the imidazole group of compounds are all effective topically. For the mouth, These are available as oral suspensions, lozenges and oral gels. False teeth should be removed at night, washed and steeped in antiseptic or a nystatin solution. For other areas of candidiasis, creams, ointments and pessaries are available. Magenta paint is also a useful but messy remedy for the skin flexures. In chronic paronychia, the nail folds can be packed with an imidazole cream or drenched in an imidazole solution several times a day. Genital candidiasis responds well to a single day's treatment with either itraconazole and fluconazole. Both are also valuable for recurrent oral candidiasis of the immunocompromised, and for the various types of chronic mucocutaneous candidiasis.Fungal Infections
Pityriasis versicolorCause
The old name, tinea versicolor, should be dropped as the disorder is caused by commensal yeasts (Pityrosporum orbiculare) and not by dermatophyte fungi. Overgrowth of these yeasts, particularly in hot humid conditions, is responsible for the clinical lesions.
Fungal Infections
Carboxylic acids released by the organisms inhibited the increase in pigment production by melanocytes that occurs normally after exposure to sunlight. The term 'versicolor' refers to the way in which the superficial scaly patches, fawn or pink on non-tanned skin, become paler than the surrounding skin after exposure to sunlight. The condition should be regarded as non-infections.Fungal Infections
Presentation and courseThe fawn or depigmented areas, with their slightly branny scaling and fine wrinkling, look ugly. Otherwise they are symptom-free or only slightly itchy. Lesions are most common on the upper trunk but can become widespread. Untreated lesions persist, and depigmented areas – even after adequate treatment – are slow to regain their former colour. Recurrences are common.
Fungal Infections
Differential diagnosisIn vitiligo, the border is clearly defined, scaling is absent, lesions are larger, the limbs and face are often affected and depigmentation is more complete; however, it may sometimes be hard to distinguish vitiligo from the pale non-scaly areas of treated versicolor. Seborrhoeic eczema of the trunk tends to be more erythematous, and is often confined to the presternal or interscapular areas. Pityriasis rosea, tinea corporis, secondary syphilis, leprosy and erythrasma seldom cause real confusion.
Fungal Infections
InvestigationsScarpings, prepared and examined as for a dermatophyte infection, show a mixture of short branched hyphae and spores (a 'spaghetti and meatballs' appearance). Cultures is not helpful because the organism does not grow on Sabouraud's medium.
Fungal Infections
Treatment
A topical preparation of one of the imidazole group of antifungal drugs can be applied at night to all affected areas for 2-4weeks. Equally effective and cheaper, but messier and more irritant, is a 2.5% selenium sulphide mixture in a detergent base (Selsun shampoo). This should be lathered on to the patches after an evening bath, and allowed to dry. Next morning it should be washed off. Three applications at weekly intervals are adequate. A shampoo containing Ketoconazole is now available, and is less messy but just as effective as the selenium ones. Alternatively, selenium sulphide lotion (USA) can be applied for 10 min, rinsed off and re-applied daily for 1 week. For widespread or stubborn infections, systemic itraconazole (200 mg/day for 7 days), fluconazole or ketoconazole may be curative, but interactions with other drugs must be avoided. Recurrence is common after ant treatment.
Fungal Infections
Deep fungal infectionsHistoplasmosis
Coccidioidomycosis
Blastomycosis
Sporotrichosis
Actinomycosis
Mycetoma (Madura foot)